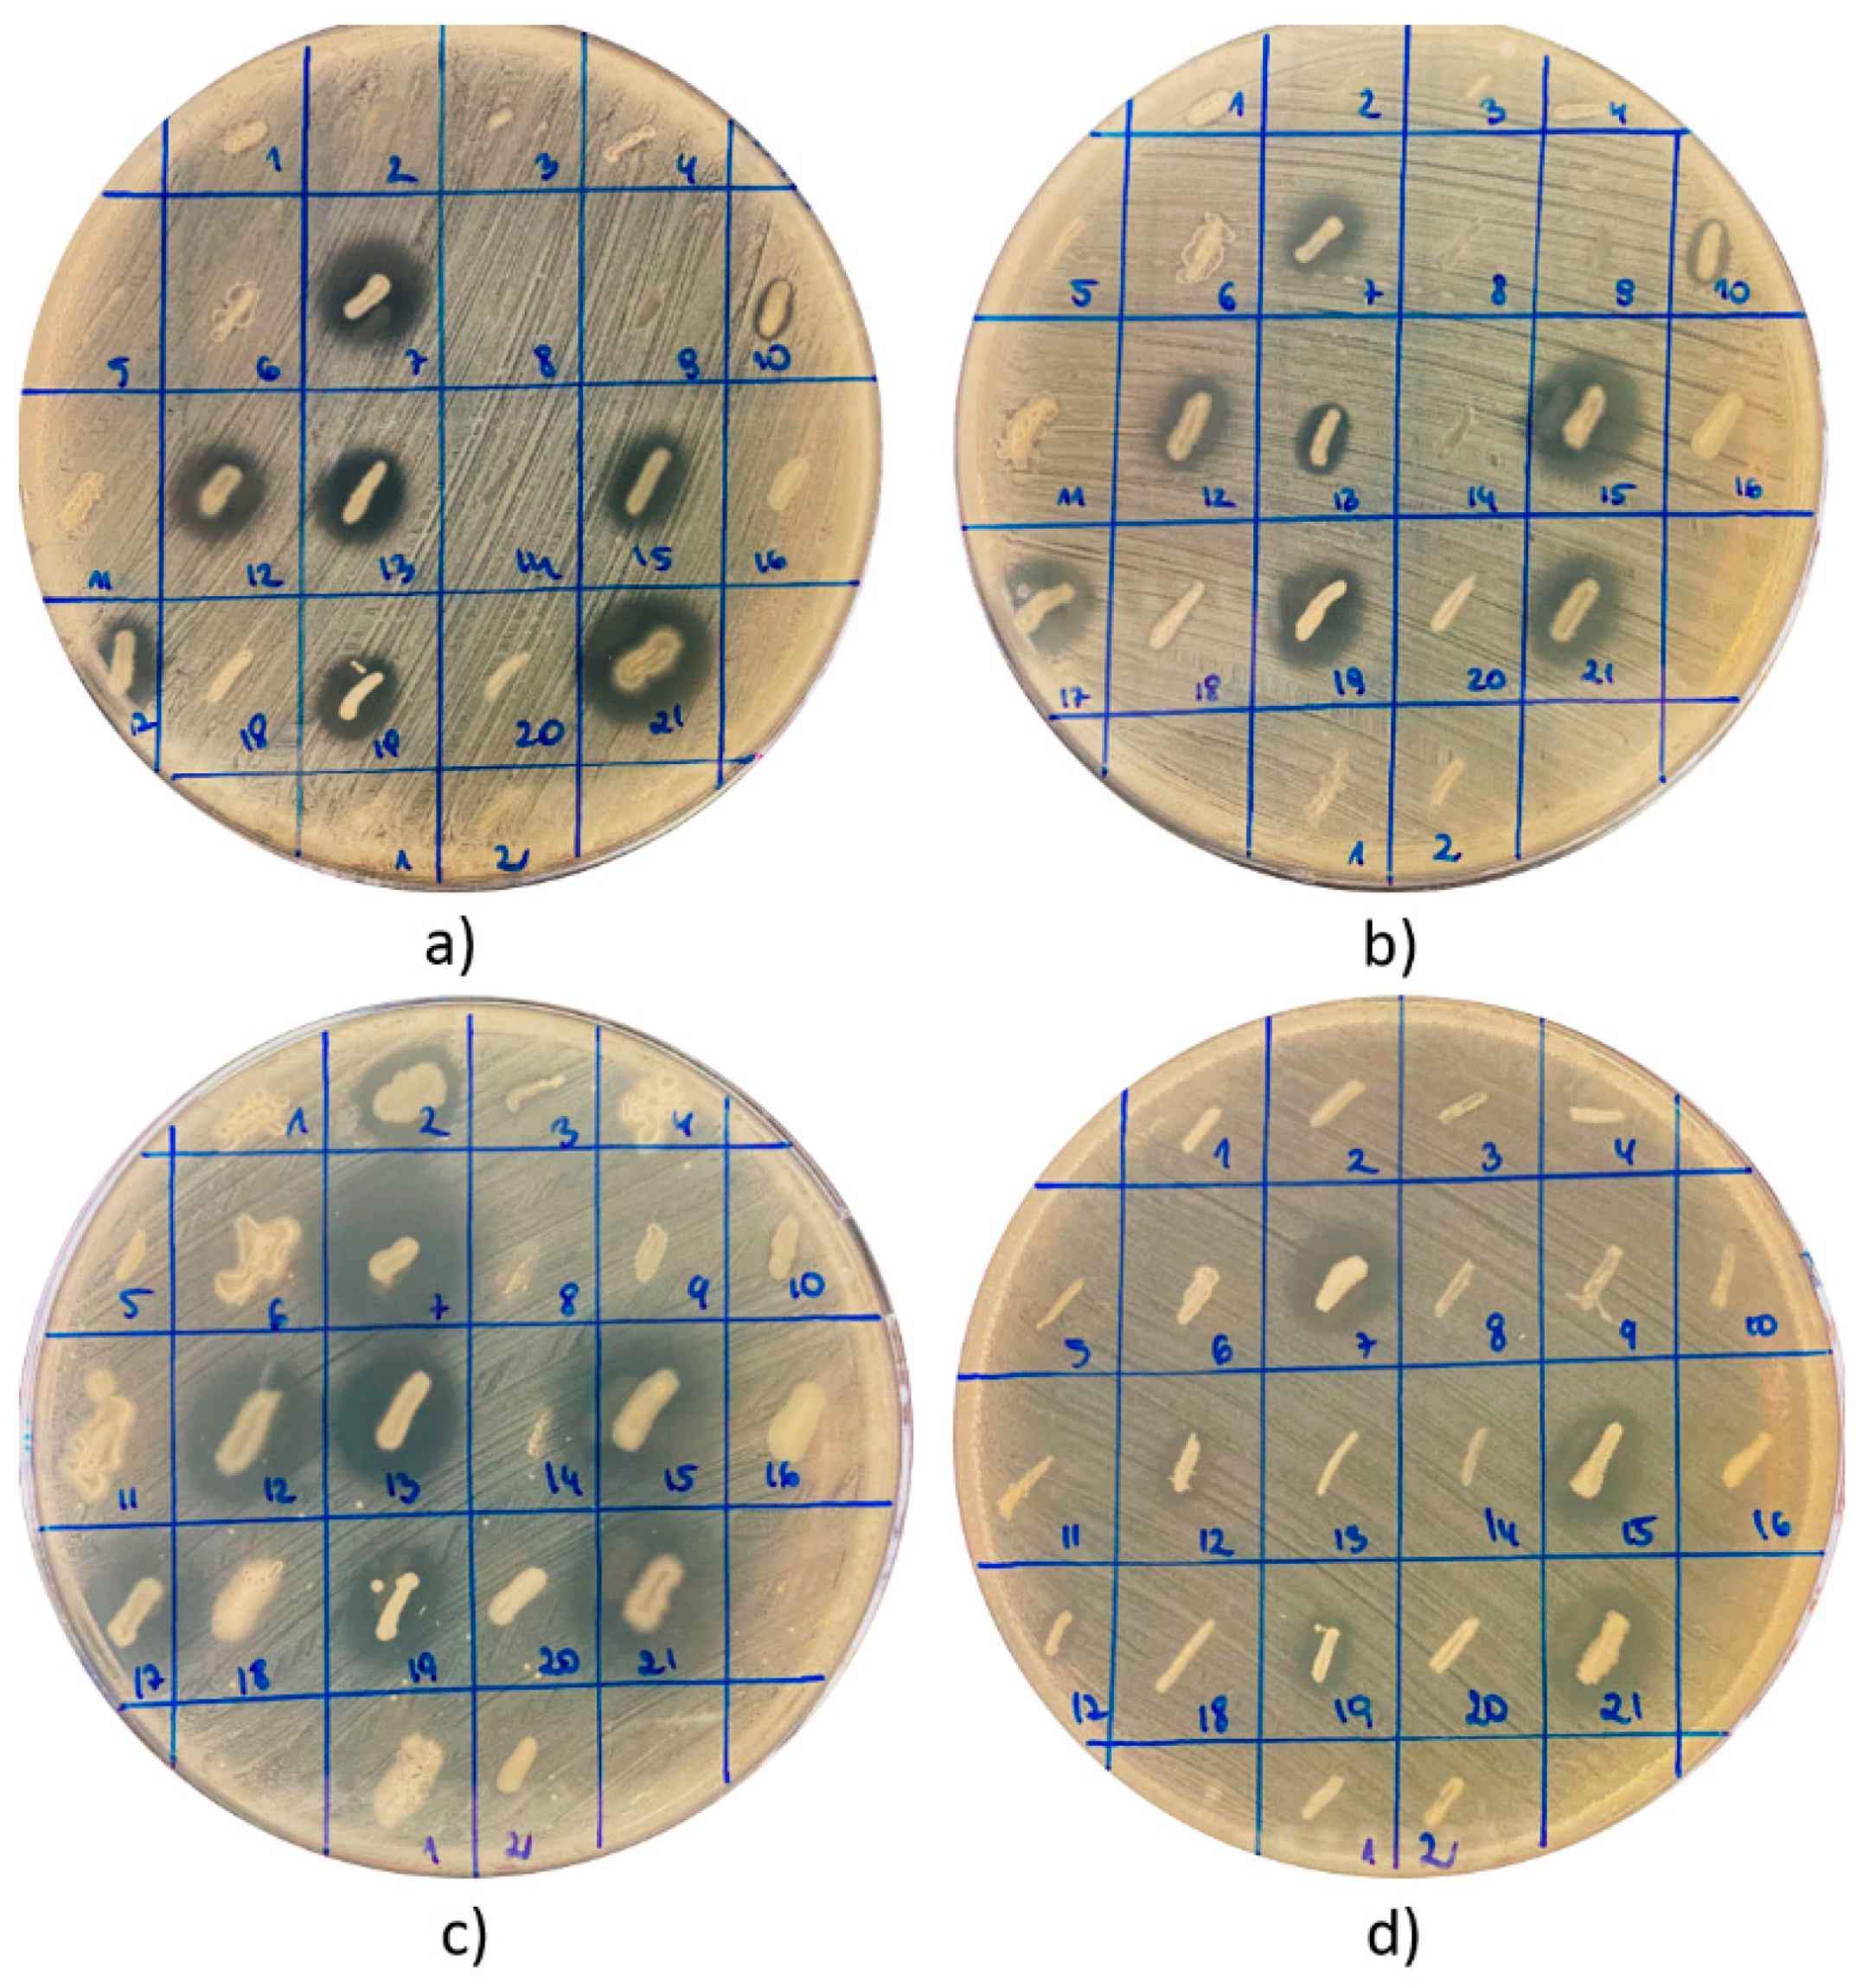
Antibiotics 10 00713 g001
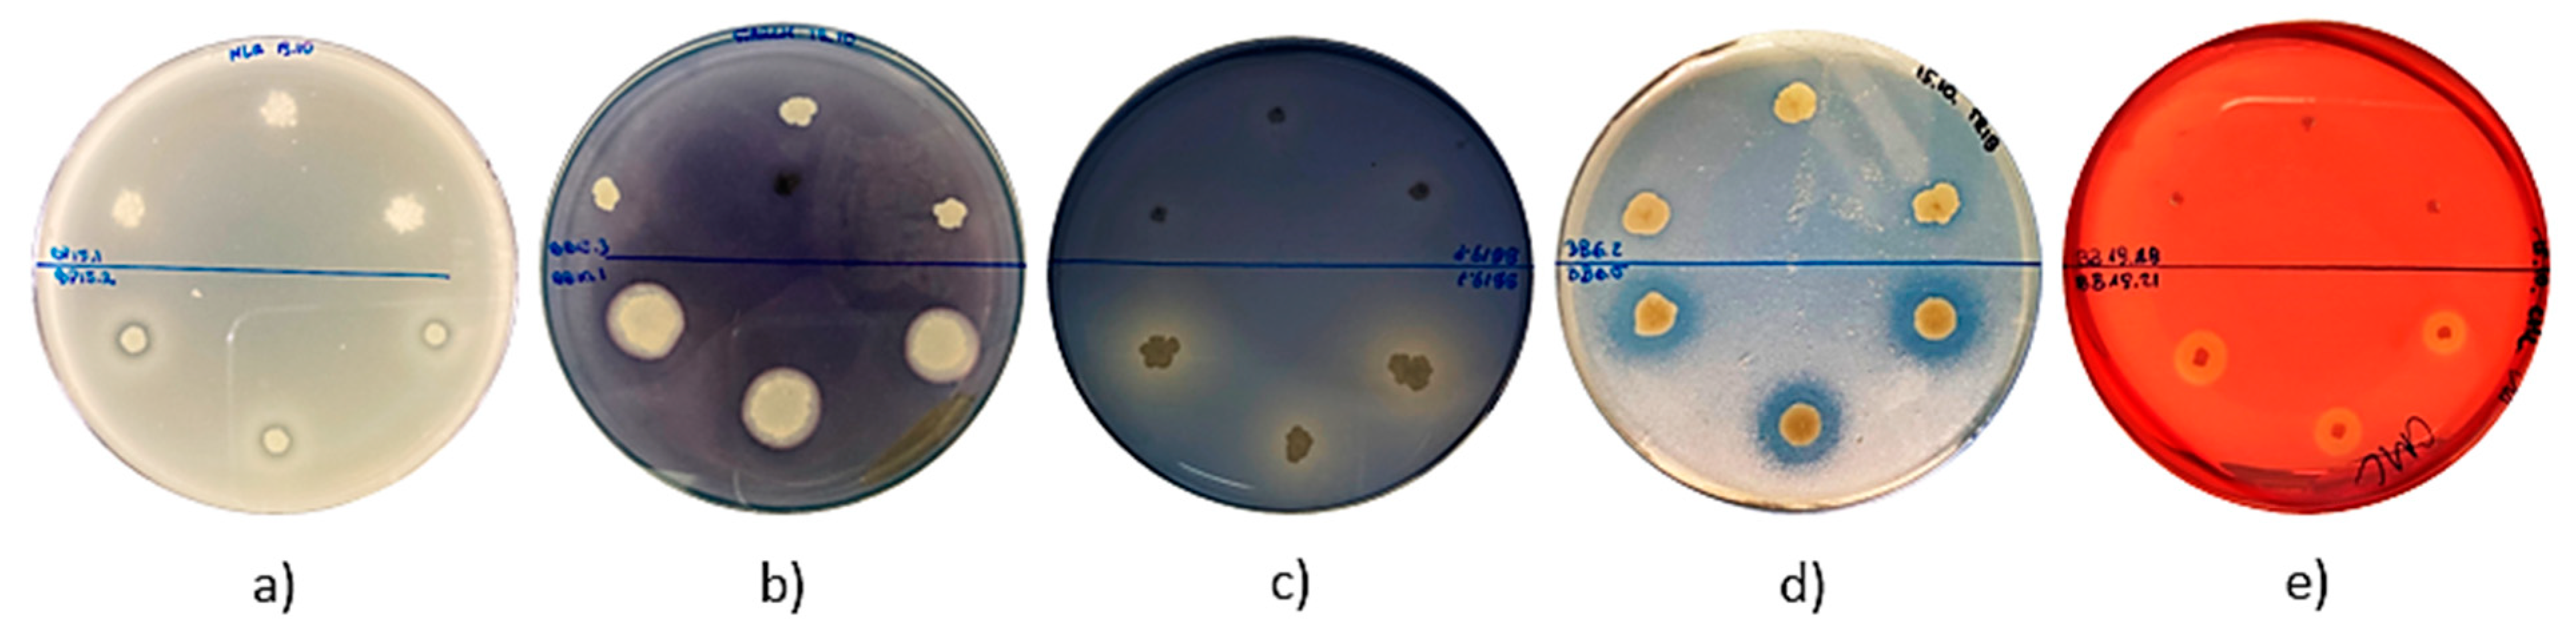
Antibiotics 10 00713 g003

Bee Pollen and Bee Bread as a Source of Bacteria Producing Antimicrobials
Abstract
1. Introduction
2. Results
3. Discussion
4. Materials and Methods
4.1. Essential Chemical Reagents and Growth Media
4.2. Bee Pollen and Bee Bread Samples and Isolation of Bacterial Strains
4.3. Growth Inhibitory Assay
4.4. Investigation of Enzymatic Activity of Isolated Strains
4.5. Identification of Bacterial Species of Isolates That Exhibited Antagonistic Activity against Selected Pathogenic Microorganisms
4.6. DNA Sequence Analysis
5. Conclusions
Author Contributions
Funding
Data Availability Statement
Acknowledgments
Conflicts of Interest
References
- Combarros−Fuertes, P.; Fresno, J.M.; Estevinho, M.M.; Sousa−Pimenta, M.; Tornadijo, M.E.; Estevinho, L.M. Honey: Another Alternative in the Fight against Antibiotic−Resistant Bacteria? Antibiotics 2020, 9, 774. [Google Scholar] [CrossRef]
- Khan, S.U.; Anjum, S.I.; Rahman, K.; Ansari, M.J.; Khan, W.U.; Kamal, S.; Khattak, B.; Muhammad, A.; Khan, H.U. Honey: Single food stuff comprises many drugs. Saudi J. Biol. Sci. 2018, 25, 320–325. [Google Scholar] [CrossRef] [PubMed]
- Silva−Carvalho, R.; Baltazar, F.; Almeida−Aguiar, C. Propolis: A complex natural product with a plethora of biological activities that can be explored for drug development. Evid. Based Complement. Alternat. Med. 2015, 2015, 206439. [Google Scholar] [CrossRef]
- Rojczyk, E.; Klama−Baryła, A.; Łabuś, W.; Wilemska−Kucharzewska, K.; Kucharzewski, M. Historical and modern research on propolis and its application in wound healing and other fields of medicine and contributions by Polish studies. J. Ethnopharmacol. 2020, 15, 113159. [Google Scholar] [CrossRef] [PubMed]
- Didaras, N.A.; Karatasou, K.; Dimitriou, T.G.; Amoutzias, G.D.; Mossialos, D. Antimicrobial Activity of Bee−Collected Pollen and Beebread: State of the Art and Future Perspectives. Antibiotics 2020, 9, 811. [Google Scholar] [CrossRef] [PubMed]
- Kwakman, P.H.; te Velde, A.A.; de Boer, L.; Speijer, D.; Vandenbroucke−Grauls, C.M.; Zaat, S.A. How honey kills bacteria. FASEB J. 2010, 24, 2576–2582. [Google Scholar] [CrossRef] [PubMed]
- Brudzynski, K. A current perspective on hydrogen peroxide production in honey. Food Chem. 2020, 332, 127229. [Google Scholar] [CrossRef] [PubMed]
- Brudzynski, K.; Sjaarda, C.P. Colloidal structure of honey and its influence on antibacterial activity. Compr. Rev. Food Sci. Food Saf. 2021, 20, 2063–2080. [Google Scholar] [CrossRef]
- Brudzynski, K.; Abubaker, K.; Miotto, D. Unraveling a mechanism of honey antibacterial action: Polyphenol/h(2)o(2)−induced oxidative effect on bacterial cell growth and on DNA degradation. Food Chem. 2012, 133, 329–336. [Google Scholar] [CrossRef] [PubMed]
- Brudzynski, K.; Miotto, D.; Kim, L.; Sjaarda, C.; Maldonado−Alvarez, L.; Fukś, H. Active macromolecules of honey form colloidal particles essential for honey antibacterial activity and hydrogen peroxide production. Sci. Rep. 2017, 7, 7637. [Google Scholar] [CrossRef]
- Bucekova, M.; Jardekova, L.; Juricova, V.; Bugarova, V.; Di Marco, G.; Gismondi, A.; Leonardi, D.; Farkasovska, J.; Godocikova, J.; Laho, M.; et al. Antibacterial Activity of Different Blossom Honeys: New Findings. Molecules 2019, 24, 1573. [Google Scholar] [CrossRef]
- Grecka, K.; Kuś, P.M.; Worobo, R.W.; Szweda, P. Study of the Anti−Staphylococcal Potential of Honeys Produced in Northern Poland. Molecules 2018, 23, 260. [Google Scholar] [CrossRef] [PubMed]
- Mavric, E.; Wittmann, S.; Barth, G.; Henle, T. Identification and quantification of methylglyoxal as the dominant antibacterial constituent of manuka (Leptospermum scoparium) honeys from New Zealand. Mol. Nutr. Food Res. 2008, 52, 483–489. [Google Scholar] [CrossRef]
- Irish, J.; Blair, S.; Carter, D.A. The antibacterial activity of honey derived from Australian flora. PLoS ONE 2011, 6, e18229. [Google Scholar] [CrossRef] [PubMed]
- Zainol, M.I.; Mohd Yusoff, K.; Mohd Yusof, M.Y. Antibacterial activity of selected Malaysian honey. BMC Complement. Altern. Med. 2013, 13, 129. [Google Scholar] [CrossRef] [PubMed]
- Przybyłek, I.; Karpiński, T.M. Antibacterial Properties of Propolis. Molecules 2019, 24, 2047. [Google Scholar] [CrossRef] [PubMed]
- Grecka, K.; Kuś, P.M.; Okińczyc, P.; Worobo, R.W.; Walkusz, J.; Szweda, P. The Anti−Staphylococcal Potential of Ethanolic Polish Propolis Extracts. Molecules 2019, 24, 1732. [Google Scholar] [CrossRef] [PubMed]
- Gucwa, K.; Kusznierewicz, B.; Milewski, S.; Van Dijck, P.; Szweda, P. Antifungal Activity and Synergism with Azoles of Polish Propolis. Pathogens 2018, 7, 56. [Google Scholar] [CrossRef]
- Curuțiu, C.; Dițu, L.M.; Grumezescu, A.M.; Holban, A.M. Polyphenols of Honeybee Origin with Applications in Dental Medicine. Antibiotics 2020, 9, 856. [Google Scholar] [CrossRef]
- Ahmad, S.; Campos, M.G.; Fratini, F.; Altaye, S.Z.; Li, J. New Insights into the Biological and Pharmaceutical Properties of Royal Jelly. Int. J. Mol. Sci. 2020, 21, 382. [Google Scholar] [CrossRef]
- Collazo, N.; Carpena, M.; Nuñez−Estevez, B.; Otero, P.; Simal−Gandara, J.; Prieto, M.A. Health Promoting Properties of Bee Royal Jelly: Food of the Queens. Nutrients 2021, 13, 543. [Google Scholar] [CrossRef]
- Fratini, F.; Cilia, G.; Turchi, B.; Felicioli, A. Beeswax: A minireview of its antimicrobial activity and its application in medicine. Asian Pac J. Trop. Med. 2016, 9, 839–843. [Google Scholar] [CrossRef] [PubMed]
- El−Seedi, H.; Abd El−Wahed, A.; Yosri, N.; Musharraf, S.G.; Chen, L.; Moustafa, M.; Zou, X.; Al−Mousawi, S.; Guo, Z.; Khatib, A.; et al. Antimicrobial Properties of Apis mellifera’s Bee Venom. Toxins 2020, 12, 451. [Google Scholar] [CrossRef]
- Kostić, A.Ž.; Milinčić, D.D.; Barać, M.B.; Ali Shariati, M.; Tešić, Ž.L.; Pešić, M.B. The Application of Pollen as a Functional Food and Feed Ingredient—The Present and Perspectives. Biomolecules 2020, 10, 84. [Google Scholar] [CrossRef]
- Kieliszek, M.; Piwowarek, K.; Kot, A.; Błażejak, S.; Chlebowska−Śmigiel, A.; Wolska, I. Pollen and bee bread as new health−oriented products: A review. Trends Food Sci. Technol. 2018, 71, 170–180. [Google Scholar] [CrossRef]
- Fatrcová−Šramková, K.; Nôžková, J.; Máriássyová, M.; Kačániová, M. Biologically active antimicrobial and antioxidant substances in the Helianthus annuus L. bee pollen. J. Environ. Sci. Health Part B 2016, 51, 176–181. [Google Scholar] [CrossRef] [PubMed]
- Didaras, N.A.; Kafantaris, I.; Dimitriou, T.G.; Mitsagga, C.; Karatasou, K.; Giavasis, I.; Stagos, D.; Amoutzias, G.D.; Hatjina, F.; Mossialos, D. Biological Properties of Bee Bread Collected from Apiaries Located across Greece. Antibiotics 2021, 10, 555. [Google Scholar] [CrossRef] [PubMed]
- Gilliam, M. Microbiology of pollen and bee bread: The yeasts. Apidologie 1979, 10, 43–53. [Google Scholar] [CrossRef]
- Disayathanoowat, T.; Li, H.; Supapimon, N.; Suwannarach, N.; Lumyong, S.; Chantawannakul, P.; Guo, J. Different Dynamics of Bacterial and Fungal Communities in Hive−Stored Bee Bread and Their Possible Roles: A Case Study from Two Commercial Honey Bees in China. Microorganisms 2020, 8, 264. [Google Scholar] [CrossRef]
- Vásquez, A.; Olofsson, T.C. The lactic acid bacteria involved in the production of bee pollen and bee bread. J. Apic. Res. 2009, 48, 189–195. [Google Scholar] [CrossRef]
- Pełka, K.; Otłowska, O.; Worobo, R.W.; Szweda, P. Bee Bread Exhibits Higher Antimicrobial Potential Compared to Bee Pollen. Antibiotics 2021, 10, 125. [Google Scholar] [CrossRef]
- Brudzynski, K. Honey as an Ecological Reservoir of Antibacterial Compounds Produced by Antagonistic Microbial Interactions in Plant Nectars, Honey and Honey Bee. Antibiotics 2021, 10, 551. [Google Scholar] [CrossRef] [PubMed]
- Casteel, D.B. The behavior of the honey bee in pollen collection. USDA Bur. Entomol. Bull. 1912, 121, 1–36. [Google Scholar]
- Komosińska−Vassev, K.; Olczyk, P.; Kaźmierczak, J.; Mencner, Ł.; Olczyk, K. Bee pollen: Chemical composition and therapeutic application. Evid. Based Complement. Altern. Med. 2015, 2015, 297425. [Google Scholar] [CrossRef] [PubMed]
- Nowak, A.; Szczuka, D.; Górczyńska, A.; Motyl, I.; Kręgiel, D. Characterization of Apis mellifera Gastrointestinal Microbiota and Lactic Acid Bacteria for Honeybee Protection—A Review. Cells 2021, 10, 701. [Google Scholar] [CrossRef] [PubMed]
- Iorizzo, M.; Lombardi, S.J.; Ganassi, S.; Testa, B.; Ianiro, M.; Letizia, F.; Succi, M.; Tremonte, P.; Vergalito, F.; Cozzolino, A.; et al. Antagonistic Activity against Ascosphaera apis and Functional Properties of Lactobacillus kunkeei Strains. Antibiotics 2020, 9, 262. [Google Scholar] [CrossRef] [PubMed]
- Iorizzo, M.; Testa, B.; Lombardi, S.J.; Ganassi, S.; Ianiro, M.; Letizia, F.; Succi, M.; Tremonte, P.; Vergalito, F.; Cozzolino, A.; et al. Antimicrobial Activity against Paenibacillus larvae and Functional Properties of Lactiplantibacillus plantarum Strains: Potential Benefits for Honeybee Health. Antibiotics 2020, 9, 442. [Google Scholar] [CrossRef]
- Detry, R.; Simon−Delso, N.; Bruneau, E.; Daniel, H.-M. Specialisation of Yeast Genera in Different Phases of Bee Bread Maturation. Microorganisms 2020, 8, 1789. [Google Scholar] [CrossRef] [PubMed]
- Pajor, M.; Worobo, R.W.; Milewski, S.; Szweda, P. The Antimicrobial Potential of Bacteria Isolated from Honey Samples Produced in the Apiaries Located in Pomeranian Voivodeship in Northern Poland. Int. J. Environ. Res. Public Health 2018, 15, 2002. [Google Scholar] [CrossRef]
- Pajor, M.; Xiong, Z.R.; Worobo, R.W.; Szweda, P. Paenibacillus alvei MP1 as a Producer of the Proteinaceous Compound with Activity against Important Human Pathogens, Including Staphylococcus aureus and Listeria monocytogenes. Pathogens 2020, 9, 319. [Google Scholar] [CrossRef]
- Pajor, M.; Sogin, J.; Worobo, R.; Szweda, P. Draft genome sequence of antimicrobial producing Paenibacillus alvei strain MP1 reveals putative novel antimicrobials. BMC Res. Notes 2020, 13, 1–6. [Google Scholar] [CrossRef] [PubMed]
- Lee, H.; Churey, J.J.; Worobo, R.W. Antimicrobial activity of bacterial isolates from different floral sources of honey. Int. J. Food Microbiol. 2008, 126, 240–244. [Google Scholar] [CrossRef] [PubMed]
- Lee, H.; Churey, J.J.; Worobo, R.W. Isolation and characterization of a protective bacterial culture isolated from honey active against American Foulbrood disease. FEMS Microbiol. Lett. 2009, 296, 39–44. [Google Scholar] [CrossRef]
- Zulkhairi Amin, F.A.; Sabri, S.; Ismail, M.; Chan, K.W.; Ismail, N.; Mohd Esa, N.; Mohd Lila, M.A.; Zawawi, N. Probiotic Properties of Bacillus Strains Isolated from Stingless Bee (Heterotrigona itama) Honey Collected across Malaysia. Int. J. Environ. Res. Public Health 2020, 17, 278. [Google Scholar] [CrossRef] [PubMed]
- Khalili Samani, M.; Noormohammadi, Z.; Fazeli, M.R. Bacteriocin activity of various iranian honey-associated bacteria and development of a simple medium for enhanced bacteriocin activity. J. Environ. Health Sci. Eng. 2021, 19, 427–435. [Google Scholar] [CrossRef]
- Markiewicz−Żukowska, R.; Naliwajko, S.; Bartosiuk, E.; Moskwa, J.; Isidorov, V.; Soroczyńska, J.; Borawska, M. Chemical composition and antioxidant activity of beebread, and its influence on the glioblastoma cell line (U87MG). J. Apic. Sci. 2013, 57, 147–157. [Google Scholar] [CrossRef]

| Sample | No. of Colonies | CFU/g of Product | Activity against S. aureus ATCC 25923 | Activity against S. aureus ATCC 29213 | Activity against S. epidermidis ATCC 12228 | Activity against E. coli ATCC 25922 | Activity against P. aeruginosa ATCC 27853 | |||||
|---|---|---|---|---|---|---|---|---|---|---|---|---|
| No. of Colonies | % | No. of Colonies | % | No. of Colonies | % | No. of Colonies | % | No. of Colonies | % | |||
| BP3 | 14 | 1400 | 6 | 42.86 | 6 | 42.86 | 5 | 35.71 | 5 | 35.71 | 7 | 50.00 |
| BP15 | 5 | 500 | 2 | 40.00 | 2 | 40.00 | 2 | 40.00 | 2 | 40.00 | 3 | 60.00 |
| BP12 | 1 | 100 | 0 | 0.00 | 0 | 0.00 | 0 | 0.00 | 0 | 0.00 | 0 | 0.00 |
| BP20 | 15 | 1500 | 6 | 40.00 | 7 | 46.67 | 3 | 20.00 | 1 | 6.67 | 7 | 46.67 |
| BB3 | 2 | 200 | 0 | 0.00 | 0 | 0.00 | 0 | 0.00 | 0 | 0.00 | 0 | 0.00 |
| BB6 | 13 | 1300 | 1 | 7.69 | 2 | 15.38 | 1 | 7.69 | 1 | 7.69 | 2 | 15.38 |
| BB10 | 6 | 600 | 3 | 50.00 | 3 | 50.00 | 3 | 50.00 | 1 | 16.67 | 3 | 50.00 |
| BB15 | 4 | 400 | 1 | 25.00 | 1 | 25.00 | 0 | 0.00 | 0 | 0.00 | 1 | 25.00 |
| BB19 | 21 | 2100 | 8 | 38.10 | 8 | 38.10 | 8 | 38.10 | 5 | 23.81 | 9 | 42.86 |
| TOTAL | 81 | 27 | 33.33 | 29 | 35.80 | 22 | 27.20 | 15 | 18.52 | 32 | 39.51 | |
| Sample | Species Classification * | Exhibited Activity | ||||
|---|---|---|---|---|---|---|
| S. aureus ATCC 25923 | S. aureus ATCC 29213 | S. epidermidis ATCC 12228 | E. coli ATCC 25922 | P. aeruginosa ATCC 27853 | ||
| BP3.2 | Bacillus spp. (pumilus, zhangzhouensis) | ++ | +++ | +++ | +++ | +++ |
| BP3.3 | Bacillus spp. (pumilus, zhangzhouensis) | + | ++ | ++ | ++ | ++ |
| BP3.7 | Bacillus spp. (pumilus, zhangzhouensis) | + | + | + | ++ | ++ |
| BP3.10 | Bacillus spp. (pumilus, zhangzhouensis) | +++ | +++ | +++ | +++ | +++ |
| BP3.11 | Bacillus spp. (altitudinis, stratosphericus) | + | + | − | − | +++ |
| BP3.12 | Bacillus spp. (licheniformis, aerius) | − | − | − | − | ++ |
| BP3.13 | Bacillus spp. (pumilus, zhangzhouensis) | +++ | +++ | +++ | +++ | +++ |
| BP15.1 | Bacillus spp. (lichemiformis) | − | − | − | − | +++ |
| BP15.3 | Bacillus spp. (pumilus, zhangzhouensis) | ++ | ++ | +++ | +++ | +++ |
| BP15.4 | Bacillus spp. (altitudinis, stratosphericus) | +++ | +++ | +++ | +++ | ++ |
| BP20.1 | Bacillus spp. (safensis, pumilus) | + | + | − | − | ++ |
| BP20.3 | Bacillus spp. (altitudinis, stratosphericus) | + | + | − | − | ++ |
| BP20.4 | Bacillus spp. (altitudinis, stratosphericus) | + | + | − | − | + |
| BP20.6 | Bacillus spp. (altitudinis, stratosphericus) | − | + | − | − | +++ |
| BP20.7 | Bacillus spp. (altitudinis, stratosphericus) | + | + | +++ | − | ++ |
| BP20.9 | Bacillus spp. (altitudinis, stratosphericus) | +++ | ++ | ++ | ++ | ++ |
| BP20.15 | Bacillus spp. (subtilis) | +++ | ++ | + | − | +++ |
| BB6.2 | Bacillus spp. (pumilus, zhangzhouensis) | +++ | ++ | +++ | ++ | ++ |
| BB6.5 | Bacillus spp. (altitudinis, stratosphericus) | − | ++ | − | − | + |
| BB10.1 | Bacillus spp. (subtilis) | +++ | +++ | +++ | − | +++ |
| BB10.3 | Bacillus spp. (pumilus, zhangzhouensis) | + | + | + | − | ++ |
| BB10.6 | Bacillus spp. (pumilus, zhangzhouensis) | +++ | +++ | +++ | +++ | +++ |
| BB15.3 | Bacillus spp. (altitudinis, stratosphericus) | + | ++ | − | − | +++ |
| BB19.2 | Bacillus spp. (pumilus, zhangzhouensis) | − | − | ++ | − | − |
| BB19.7 | Bacillus spp. (pumilus, zhangzhouensis) | +++ | ++ | +++ | +++ | +++ |
| BB19.9 | Bacillus spp. (licheniformis, aerius) | − | − | − | − | ++ |
| BB19.10 | Bacillus spp. (altitudinis, aerius) | + | + | − | − | + |
| BB19.11 | Bacillus spp. (licheniformis, paralicheniformis) | − | − | − | − | +++ |
| BB19.12 | Bacillus spp. (pumilus, zhangzhouensis) | ++ | ++ | +++ | + | +++ |
| BB19.13 | Bacillus spp. (pumilus, zhangzhouensis) | +++ | ++ | +++ | − | ++ |
| BB19.15 | Bacillus spp. (pumilus, zhangzhouensis) | ++ | +++ | +++ | +++ | +++ |
| BB19.17 | Bacillus spp. (pumilus, zhangzhouensis) | +++ | +++ | ++ | − | +++ |
| BB19.19 | Bacillus spp. (pumilus, zhangzhouensis) | +++ | +++ | ++ | ++ | − |
| BB19.21 | Bacillus spp. (pumilus, zhangzhouensis) | +++ | +++ | +++ | +++ | +++ |
| Isolates | Proteolytic Activity | Amylolytic Activity | Lipolytic Activity | Esterolytic Activity | Cellulolytic Activity | Presence of Beta−Galactosidase | Presence of Laccase | |
|---|---|---|---|---|---|---|---|---|
| 1 | BP3.1 | − | − | − | − | − | − | − |
| 2 | BP3.2 | +++ | − | + | − | ++ | − | − |
| 3 | BP3.3 | ++ | − | ++ | − | ++ | − | − |
| 4 | BP3.4 | − | − | − | − | − | − | − |
| 5 | BP3.5 | +++ | − | ++ | ++ | +++ | − | − |
| 6 | BP3.6 | + | − | + | − | + | − | − |
| 7 | BP3.7 | + | − | ++ | ++ | − | − | − |
| 8 | BP3.8 | − | − | − | − | − | − | − |
| 9 | BP3.9 | − | +++ | ++ | ++ | +++ | + | − |
| 10 | BP3.10 | +++ | − | ++ | − | ++ | − | − |
| 11 | BP3.11 | + | − | + | − | + | − | − |
| 12 | BP3.12 | − | − | +++ | + | +++ | + | − |
| 13 | BP3.13 | ++ | − | + | − | ++ | − | − |
| 14 | BP3.14 | + | − | + | − | + | − | − |
| 15 | BP12.1 | ++ | − | +++ | − | ++ | + | − |
| 16 | BP15.1 | − | − | +++ | − | ++ | − | − |
| 17 | BP15.2 | ++ | − | + | + | ++ | − | − |
| 18 | BP15.3 | +++ | − | ++ | − | ++ | − | − |
| 19 | BP15.4 | + | − | ++ | − | +++ | − | − |
| 20 | BP15.5 | − | − | ++ | − | − | − | − |
| 21 | BP20.1 | ++ | − | ++ | − | − | − | − |
| 22 | BP20.2 | ++ | − | +++ | − | + | + | − |
| 23 | BP20.3 | ++ | − | ++ | + | +++ | − | − |
| 24 | BP20.4 | ++ | − | ++ | + | ++ | − | − |
| 25 | BP20.5 | − | − | +++ | − | + | − | − |
| 26 | BP20.6 | +++ | − | ++ | + | ++ | − | − |
| 27 | BP20.7 | ++ | − | ++ | + | ++ | − | − |
| 28 | BP20.8 | ++ | − | +++ | − | − | + | − |
| 29 | BP20.9 | ++ | − | ++ | + | +++ | − | − |
| 30 | BP20.10 | ++ | − | − | − | − | − | − |
| 31 | BP20.11 | − | − | + | − | + | + | − |
| 32 | BP20.12 | − | − | + | ++ | − | − | − |
| 33 | BP20.13 | − | − | − | − | − | − | − |
| 34 | BP20.14 | − | − | − | − | − | − | − |
| 35 | BP20.15 | +++ | +++ | +++ | + | +++ | − | − |
| 36 | BB3.1 | − | − | ++ | − | +++ | − | − |
| 37 | BB3.2 | − | − | − | − | − | − | − |
| 38 | BB6.1 | − | − | ++ | − | − | + | − |
| 39 | BB6.2 | +++ | − | ++ | + | ++ | − | − |
| 40 | BB6.3 | − | − | ++ | − | − | + | − |
| 41 | BB6.4 | − | − | − | − | − | − | − |
| 42 | BB6.5 | − | − | +++ | +++ | ++ | − | − |
| 43 | BB6.6 | − | − | − | − | − | − | − |
| 44 | BB6.7 | − | − | + | − | − | − | − |
| 45 | BB6.8 | ++ | − | ++ | − | + | + | − |
| 46 | BB6.9 | − | − | +++ | − | − | − | − |
| 47 | BB6.10 | − | − | − | − | − | − | − |
| 48 | BB6.11 | − | − | + | ++ | +++ | − | − |
| 49 | BB6.12 | − | − | +++ | − | +++ | − | − |
| 50 | BB6.13 | − | − | ++ | + | ++ | − | − |
| 51 | BB10.1 | + | +++ | + | ++ | +++ | − | − |
| 52 | BB10.2 | − | − | +++ | − | ++ | − | − |
| 53 | BB10.3 | + | − | ++ | ++ | + | − | − |
| 54 | BB10.4 | − | − | +++ | − | ++ | − | − |
| 55 | BB10.5 | − | − | +++ | − | +++ | + | − |
| 56 | BB10.6 | ++ | − | + | ++ | ++ | − | − |
| 57 | BB15.1 | − | − | + | + | + | − | − |
| 58 | BB15.2 | − | − | + | − | + | − | − |
| 59 | BB15.3 | + | − | + | + | ++ | − | − |
| 60 | BB15.4 | − | − | +++ | − | +++ | − | − |
| 61 | BB19.1 | − | − | +++ | − | ++ | − | − |
| 62 | BB19.2 | +++ | − | ++ | + | + | − | − |
| 63 | BB19.3 | − | − | ++ | − | − | − | − |
| 64 | BB19.4 | − | − | ++ | − | − | − | − |
| 65 | BB19.5 | − | − | ++ | + | − | − | − |
| 66 | BB19.6 | + | − | ++ | − | ++ | − | − |
| 67 | BB19.7 | + | − | +++ | + | ++ | − | − |
| 68 | BB19.8 | − | − | ++ | − | − | − | − |
| 69 | BB19.9 | − | − | − | + | + | − | − |
| 70 | BB19.10 | ++ | − | ++ | − | +++ | − | − |
| 71 | BB19.11 | − | − | + | − | + | + | − |
| 72 | BB19.12 | +++ | − | ++ | + | +++ | − | − |
| 73 | BB19.13 | ++ | − | ++ | + | ++ | − | − |
| 74 | BB19.14 | − | − | + | − | − | − | − |
| 75 | BB19.15 | + | − | ++ | − | +++ | − | − |
| 76 | BB19.16 | − | − | − | − | − | − | − |
| 77 | BB19.17 | ++ | − | +++ | − | +++ | − | − |
| 78 | BB19.18 | − | − | ++ | − | − | − | − |
| 79 | BB19.19 | ++ | − | +++ | + | − | − | − |
| 80 | BB19.20 | − | − | ++ | − | ++ | − | − |
| 81 | BB19.21 | +++ | − | +++ | + | +++ | − | − |
| TOTAL | ||||||||
| S | 10 (12%) | 3 (4%) | 19 (23%) | 1 (1%) | 18 (22%) | 0 (0%) | 0 | |
| M | 18 (22%) | 0 | 33 (41%) | 8 (10%) | 23 (28%) | 0 (0%) | 0 | |
| W | 11 (14%) | 0 | 17 (21%) | 20 (25%) | 13 (16%) | 11 (14%) | 0 | |
| L | 42 (52%) | 78 (96%) | 12 (15%) | 52 (64%) | 27 (33%) | 70 (86%) | 81 (100%) | |
Publisher’s Note: MDPI stays neutral with regard to jurisdictional claims in published maps and institutional affiliations. |
© 2021 by the authors. Licensee MDPI, Basel, Switzerland. This article is an open access article distributed under the terms and conditions of the Creative Commons Attribution (CC BY) license (https://creativecommons.org/licenses/by/4.0/).
Share and Cite
Pełka, K.; Worobo, R.W.; Walkusz, J.; Szweda, P. Bee Pollen and Bee Bread as a Source of Bacteria Producing Antimicrobials. Antibiotics 2021, 10, 713. https://doi.org/10.3390/antibiotics10060713
Pełka K, Worobo RW, Walkusz J, Szweda P. Bee Pollen and Bee Bread as a Source of Bacteria Producing Antimicrobials. Antibiotics. 2021; 10(6):713. https://doi.org/10.3390/antibiotics10060713
Chicago/Turabian StylePełka, Karolina, Randy W. Worobo, Justyna Walkusz, and Piotr Szweda. 2021. "Bee Pollen and Bee Bread as a Source of Bacteria Producing Antimicrobials" Antibiotics 10, no. 6: 713. https://doi.org/10.3390/antibiotics10060713
APA StylePełka, K., Worobo, R. W., Walkusz, J., & Szweda, P. (2021). Bee Pollen and Bee Bread as a Source of Bacteria Producing Antimicrobials. Antibiotics, 10(6), 713. https://doi.org/10.3390/antibiotics10060713

